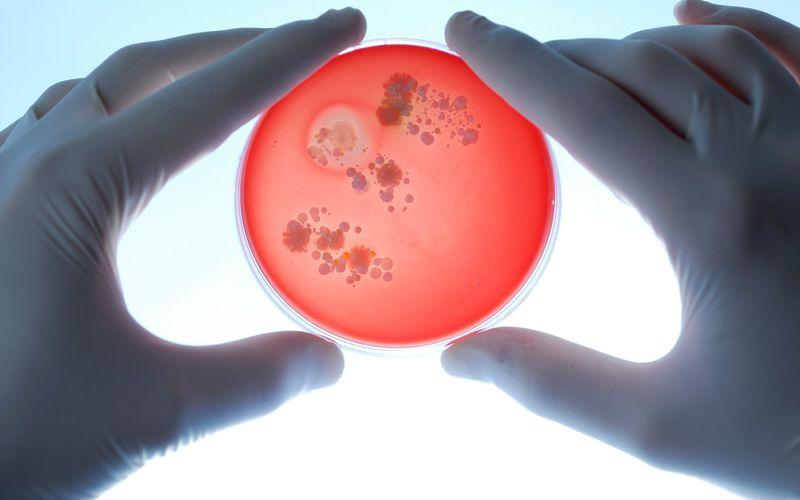

AGAR BIPLACA SANGRE MACCONKEY MDM CAJA 90MM X 15MM MDM Científica

Agar sangre con estría estafilocócica. Muchas bacterias y levaduras sintetizan y secretan NAD (factor V) durante el crecimiento, tal es el caso de Staphylococcus aureus. En cultivos mixtos, las especies de Haemophilus que requieren este factor pueden crecer como colonias puntiformes alrededor de las colonias de estos otros microorganismos.
Staphylococcus Saprophyticus Agar Sangre Microbiolog A Bacteriologia The Best Porn Website

El Agar Estafilococos No. 110 es utilizado para el aislamiento y diferenciación de estafilococos en base a la fermentación de manitol, la formación de pigmento y la hidrólisis de gelatina. FÓRMULA: (aproximada en g/L) PREPARACIÓN: Método. Suspender 149 g del medio en un litro de agua purificada. Calentar con agitación suave hasta su.
Agar sangre qué es, fundamento, usos y preparación
S. aureus genera bacteriemia, que con frecuencia causa focos metastásicos de infección, puede producirse a partir de cualquier infección localizada por S. aureus, pero es particularmente común después de infecciones relacionadas con catéteres vasculares u otros cuerpos extraños.También puede producirse sin un sitio primario evidente. S. epidermidis y otros estafilococos coagulasa.
Cultivo de agar sangre. medicne microbiology Petri dishes, Food, Dishes

Study with Quizlet and memorize flashcards containing terms like AGAR NUTRITIVO 1, AGAR NUTRITIVO 2, AGAR NUTRITIVO 3 and more.
1. Cultivo en el medio Agar sangre (Staphylococcus aureus). Download Scientific Diagram

Agar sangre con estría estafilocócica Muchas bacterias y levaduras sintetizan y secretan NAD (factor V) durante el crecimiento, tal es el caso de Staphylococcus aureus. En cultivos mixtos, las especies de Haemophilus que requieren este factor pueden crecer como colonias puntiformes alrededor de las colonias de estos otros microorganismos.
Blood agar plate showing (a) small colony variant (b) normal variant of... Download Scientific

Las especies coagulasa-negativas tales como S. epidermidis se asocian cada vez más con las infecciones intrahospitalarias; S. saprophyticus causa infecciones urinarias.S. lugdunensis, una especie coagulasa negativa, puede causar enfermedades graves con una virulencia similar a la de S. aureus.A diferencia de la mayoría de las especies de estafilococos coagulasa negativos, S. lugdunensis.
Streptococcus Pneumoniae On Blood Agar Sudded

sión homogénea. Calentar con agitación frecuente y hervir 1 minuto para disolución total. Esterilizar a 121 ºC durante 20 minutos. Preparación de Agar Sangre: Agregar 5-10 % de sangre ovina desfibrinada estéril (Britasheep) al medio esterilizado, fundido y enfriado a 45-50 ºC. Homogeneizar y distribuir en placas de Petri estériles.
Blood Agar Definition, Preparation, Composition, Application, and limitation.

Bienvenidos a nuestro último artículo donde nos adentraremos en el mundo de la microbiología. Conoceremos los tipos de agar, una herramienta fundamental para el crecimiento y análisis de microorganismos. Descubre cómo estos medios de cultivo permiten explorar el increíble universo invisible del agua. ¡Adéntrate con nosotros en este apasionante tema! Descubriendo los Diferentes Tipos de
Pin page

Estudia con Quizlet y memoriza fichas que contengan términos como Valores normales del LCR, Meningitis purulenta y meningitis aséptica, Meningitis aguda y crónica y muchos más.. - Agar BHI con sangre. Agar para Neisseria meningitidis. Agar thayer martin. Agar para Haemophilus influenzae. Agar sangre de caballo con estría estafilocócica.
PLACA PETRI CON AGAR SANGRE, comprar online

A. Microorganismos típicos. Los estafilococos son bacterias esféricas de casi 1 µm de diámetro dispuestas en racimos irregulares ( figura 13-1 ). También se observan cocos individuales, pares, tétradas y cadenas en medios de cultivo líquidos. Los cocos jóvenes son intensamente grampositivos; al envejecer, muchas células se vuelven.
Colonias con B hemolysis. Agar sangre Jewelry, Rings

A menudo, los síntomas también desaparecen rápidamente y, con frecuencia, duran solo medio día. Por lo general, una infección por estafilococos en los alimentos no provoca fiebre. Los signos y síntomas que puedes esperar con este tipo de infección por estafilococos incluyen lo siguiente: Náuseas y vómitos. Diarrea.
Crecimiento de staphylococcus aureus en agar sangre Foto Premium

Los miembros del género Staphylococcus (estafilococos) son cocos grampositivos que tienden a disponerse en racimos similares a uvas ( figura 24-1 ). A nivel mundial, Staphylococcus aureus es una de las causas más comunes de infecciones purulentas agudas. Otras especies son comunes en la flora cutánea, pero producen enfermedades de baja.
AGAR SANGRE DE CORDERO BIOBACTER

siembra por agotamiento en la superficie del agar sangre, se realicen varias punzadas con la misma asa bacterioló-gica en un área sin estrías de agotamiento. Con ello se consigue, en la zona subsuperficial, potenciar la actividad hemolítica de la hemolisina, tanto la estable al oxígeno como la que es lábil a este gas. Otro factor.
Thermo Scientific™ Agar Columbia con agar sangre/chocolate Ver productos Fisher Scientific

Nombre medio - característica (rico, diferencial, selectivo) Learn with flashcards, games, and more — for free.
Agar Sangre ubicaciondepersonas.cdmx.gob.mx

Agar sangre con estría estafilocócica . Muchas bacterias y levaduras sinteti zan y secretan N AD (factor V) durante el crecimiento, tal es el caso de . Staphylococcus aureus. En cultivos mixtos, las especies de Haemophilus que requieren este factor pueden crecer .
AGAR SANGRE MDM CAJA 90MM X 15MM MDM Científica

Incluye lactosa y sacarosa. Rojo fenol como indicador. Selectivo y Diferencial Aislamiento selectivo de especies de , salvo y No se recomienda para Colonias de rosas, blancas o transparentes, dependiendo de la fermentación de los azúcares. Agar chocolate con Isovitalex y vancomicina Agar sangre, con la sangre lisada (por calentamiento a 80ºC).